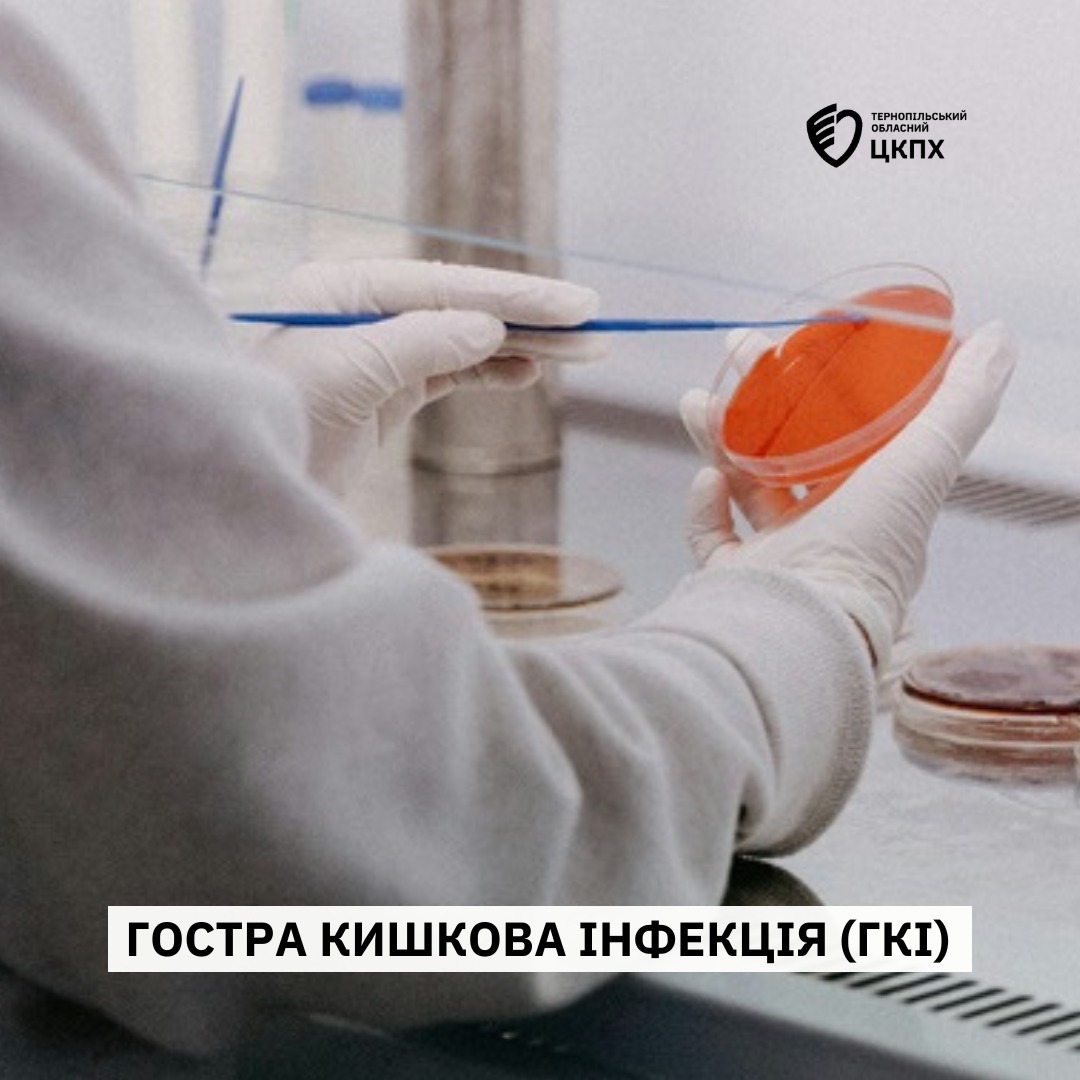

Гостра кишкова інфекція
19 листопада 2024
Гостра кишкова інфекція (ГКІ) – це група захворювань, збудниками яких є віруси і бактерії, що вражають слизову оболонку шлунка і кишечника (рідше ротоглотки). Потрапляючи в травний тракт, вони провокують нудоту, гастрит з блювотою, гостру діарею і як наслідок- зневоднення організму.
Характерні симптоми включають загальну інтоксикацію (отруєння), яка може проявлятися в легкій, помірній та тяжкій формі. Захворювання вражає дітей, дорослих і людей похилого віку. Найбільш небезпечна ГКІ для пацієнтів у віці до 2 років і людей з хронічними хворобами шлунково-кишкового тракту.
Причина виникнення кишкових інфекцій – проникнення вірусів, бактерій і їх токсинів через ротоглотку в шлунок і далі в кишківник. При розмноженні вони викликають запалення, виділяють отрути і небезпечні токсини. Як правило, захворювання розвивається через 6-48 годин, але може мати і більш тривалий інкубаційний період. На відміну від ГРВІ та сезонного грипу, пік яких припадає на холодну пору року, кишковий грип, ротавірусний ентерит (запалення кишечника), дизентерія частіше спостерігаються влітку.
Головні шляхи поширення інфекції – контактно-побутовий, через воду та продукти харчування, а також повітряно-крапельним шляхом (ротавірус). Джерелом інфекції можуть бути блювотні маси і фекалії вірусоносіїв, у яких хвороба проявляється безсимптомними формами.
Найбільш поширеними видами кишкових інфекцій серед пацієнтів всіх вікових категорій є:
Ротавірусна інфекція. Джерело захворювання – ротавіруси, що провокують кишковий, шлунковий грип, ентерит. Шляхи передачі:від хворої людини до здорової, через ряд продуктів харчування, немиті руки. Даний вид вірусів є дуже стійким і може тривалий час зберігати життєздатність. Не гине при митті звичайною водою або низьких температурах. Знищується кип’ятінням (вода, молоко) і тепловою обробкою.
Норовірусна інфекція. Хвороба викликає різновид ентеровірусів Caliciviridae, що провокують розвиток ГКІ. Механізм передачі: через предмети побуту, їжу, рідини, орально-фекальним способом. Влітку причиною хвороби є немиті овочі та фрукти.
Дизентерія (шигельоз). Переносник-патогенні бактерії (дизентерійна паличка), яка виділяє токсин, що впливає на травлення і загальне самопочуття. Шляхи передачі – некип’ячене молоко, немиті свіжі продукти, неочищена вода, брудні руки. Легко заразитися від хворої людини.
Стафілококове харчове отруєння. Збудники – хвороботворні мікроорганізми (стафілокок). Шляхи поширення – продукти харчування, які пройшли недостатню термічну обробку. Серед тих, хто може бути джерелами зараження їжі стафілококами – носій захворювання в стертій формі. Дитина може заразитися від матері через грудне молоко.
Сальмонельоз. Хвороба, часто протікає у важкій формі. Передається через продукти тваринного походження, сирі яйця. Причиною може стати порушення особистої гігієни, контакт із зараженими тваринами і хворими людьми.
Нерідко пацієнти, у яких виявлена в аналізах кишкова паличка (ешерихія колі), також мають ознаки розладу травлення. Небезпечними є лише деякі штами даної бактерії, вони можуть викликати діарею мандрівника, інфекції сечового міхура, коліт. Як і ГКІ, вони вимагають обов’язкової діагностики і лікування (іноді в умовах стаціонару).
Симптоми кишкової інфекції. Основною ознакою, що дозволяє швидко відрізнити ГКІ від інших хвороб шлунково-кишкового тракту, є раптовий гострий початок. До виникнення типових проявів може спостерігатися короткочасна слабкість, зниження апетиту, сонливість, загальне погіршення самопочуття.
Симптоматика захворювання безпосередньо пов’язана зі збудником і залежить від наявності супутніх і хронічних хвороб шлунково-кишкового тракту.
Своєчасне звернення до сімейного лікаря допоможе уникнути ускладнень кишкових інфекцій і скоріше видужати.



